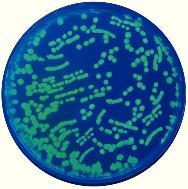

Transformation Of E Coli W Gfp, Kit Of 1
$ 146.37
|
|
Details:
TRANSFORMATION OF E COLI W GFP
Additional Information
| SKU | 23297211 |
|---|---|
| UOM | Kit of 1 |
| UNSPSC | 60100000 |
| Manufacturer Part Number | 223 |
| Product Dimensions | 1X1X1 Inches |
| Product Weight | 1 |
